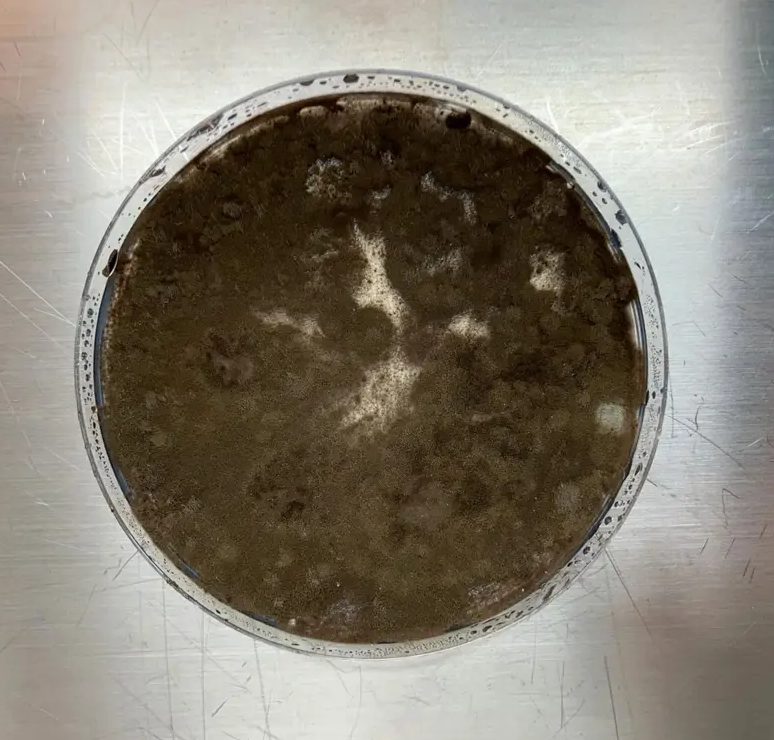
Ученые обнаружили чернобыльскую плесень, которая развила неожиданную ”суперсилу” - фото 2

Рубрики
МЕНЮ
Slava Kot
Около 40 лет после аварии на ЧАЭС Чернобыльская зона отчуждения остается местом, где природа ведет себя довольно неожиданно. Одно из самых впечатляющих открытий, которое удалось сделать, стала черная плесень, способная не только выживать в зоне высокой радиации, но и активно расти благодаря ее энергии. Новые исследования показывают, что этот гриб может стать ключом к очистке радиоактивных территорий и даже к защите астронавтов в космосе.

Плесень в Чернобыле развила способность поглощать радиацию. Фото из открытых источников
Впервые необычные грибные колонии подметила украинский микробиолог Нелли Жданова, которая вместе с командой НАН Украины исследовала разрушенный реактор в 1997 году. В помещениях, куда годами не ступала нога человека, ученые обнаружили 37 видов грибов, среди которых была черная плесень, неожиданно "тянувшаяся" к источникам радиации. В отличие от большинства живых организмов, чье развитие радиация блокирует или уничтожает, эти грибы росли в сторону загрязненных участков.
Последующие исследования показали, что грибок Cladosporium sphaerospermum не просто терпит радиацию, а он поглощает ее, используя в качестве источника энергии. Этот процесс получил название радиосинтез, аналог фотосинтеза у растений, только вместо солнечного света гриб использует ионизирующее излучение. Решающую роль в этом процессе играет меланин. Этот пигмент окрашивает плесень в темный цвет и позволяет преобразовывать радиацию в энергию для роста.
Изолят Cladosporium sphaerospermum из Чернобыля. Фото: Nils Averesch/Aaron Berliner
В 2007 году эта теория получила научное подтверждение благодаря работе Екатерины Дадачевой из Нью-Йорка. Опыты показали, что меланизированные чернобыльские грибы растут на 10% быстрее под действием радиоактивного цезия. Это значит, что они не просто выдерживают радиацию, а преуспевают благодаря ей.
Такое открытие может иметь широкое применение. Радиотропные грибы рассматривают как потенциальный инструмент для очистки сильно загрязненных территорий, например в Чернобыле или Фукусимы. Кроме того, NASA изучает возможность создания биологических защитных стен из грибов для космических кораблей, которые могли бы поглощать опасное космическое излучение.
Ранее портал "Комментарии" сообщал, что женщина придумала для дочери имя в честь Чернобыльской катастрофы.
Также "Комментарии" писали, что нашли причину, почему собаки в Чернобыле стали синего цвета.